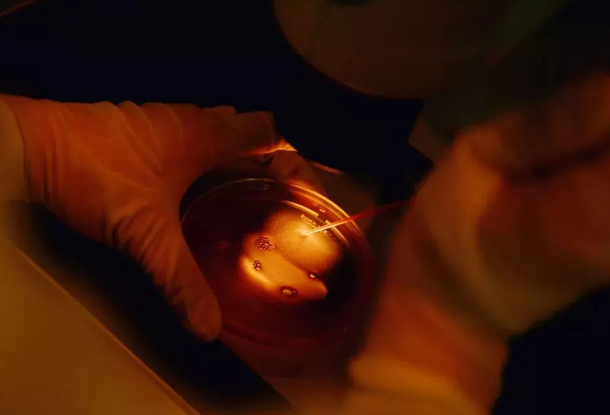
QQ图片20190408112239.png

如今科学技术发展迅猛�,试管婴儿给现代女性更多怀孕生子的机会。但与此同时也会有很多小姐妹担忧����,明明取出了十几枚卵子,较后胚胎怎么只有几个可移植胚胎?

试管婴儿技术是将精子和卵子取出体内进行结合后移植入女性体内的方式�,精子可以一次取很多,那么对女性来说�,是不是卵子取得多,就能提高试管婴儿的成功率?
取卵手术是怎样的?
通过阴道B超的引导�����,医生将取卵针穿过卵巢吸取卵子�����,并立即在显微镜下取出的卵子移到含有胚胎培养液的培养皿中�,置于37℃的培养箱中培养。
当注射HCG后试管婴儿达到较佳的取卵时间时��,由于卵泡发育的大小不相同����,卵子的成熟阶段并不完全一致�����,因此是会有卵子数量上的差异的����。
试管婴儿取卵个数过犹不及
原则上讲�,取卵的数量对试管技术的成功率是会有影响的,因为并不是每个取出的卵子都能够成功受精����,也不是每个受精卵都能发育成为有活力的胚胎��,更不是每个胚胎都能顺利着床����,故而取出多个卵子才能有足够的几率得到可移植的胚胎,这也就是促排的意义����。
然而,虽然卵子的质量和数量会影响试管技术的成功率���,但这并不代表取卵越多成功率就越高�。研究表明,每次取卵8至12个较好����,过多的取卵不仅会伤害母体,还会增加过度刺激卵巢的风险��,从而影响胚胎的移植��。
获卵越多(>20枚)�����,卵巢过度刺激综合征的风险就越高�����,伴随着恶心�、呕吐、腹胀痛等不适症状出现��,严重甚至会有生命危险���。
另外�����,卵子产生的过高的雌激素对子宫内膜和胚胎也会有不良影响�����。
总而言之��,泰国试管婴儿取卵多的确对提高成功率有一定的帮助�,但并不起决定性作用。加之过度取卵可能引起的风险应尽量规避����,因此切不可为了成功率盲目多取卵而伤害到身体,小姐妹们应谨遵医嘱���,按照实际身体情况做选择。

